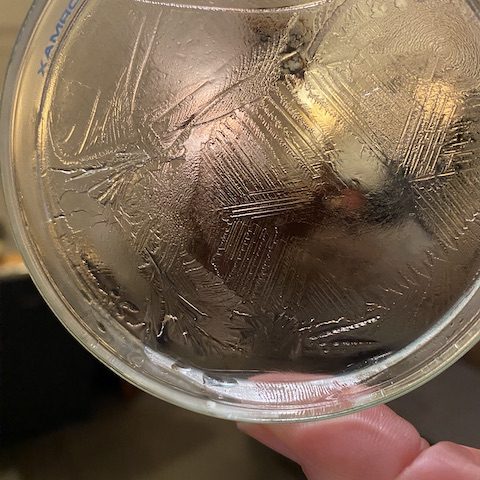

NL Water is alles dat wij als mens ook kunnen zijn met als uitzondering dat het niet oordeelt. Water is beweging, speels, spiegeling, stilte, leven, geeft leven, is bewust, kunst, mysterieus, herinnert alles, bedreigt, kalmeert, heelt, neutraal, Water is één.
Wij zijn 99% Water!
EN Water is all that we as humans can be too, accept she has no judgement.
Water moves, mirrors, is playfull, is silence, is alive, gives life, is concious, neutral, art,
mystic, she remembers all, threatens, calms, heals, Water is Oneness.
We are 99% Water!
Reflecties van water

NL Spiegelt
EN Mirrors

NL Stilte
EN Silence

NL Mystiek
EN Mystic

NL Beweegt
EN Movement
ijsbloemen communicerend op mijn dakraam

NL Libel als symbool voor grote transformatie.
EN Dragonfly as symbool of great transformation.

NL Water is Kunst met diepgaande boodschappen voor ons.
EN Water is Art with a deep message for us.


NL IJsvogel op een schildering die in mijn slaapkamer staat, als kado symbool van een vriendin in Nieuw Zeeland voor onze telepathische connectie werd geprojecteerd in de ijsbloemen op mijn dakraam.
EN Kingfisher mirrored painting in my bedroom, given as a symbolic present by my friend in
New Zealand www.earthmissioncommand.world as symbol for our telepathic connection, projected in the ice flower
on my bedroom window
Chrystalographie
NL
Een paar jaar geleden leerde ik online van Veda Austin (Nieuw Zeeland) over de technique hoe je de boodschap die Water voor je heeft kunt krijgen via ‘chrystalographie’. Zo zal ik dit proces van invriezen blijven noemen.
1/3 water in een petri schaaltje doen, zo neutraal mogelijk een vraag stellen of het water uit zichzelf laten zien wat ze op dat moment wil creëren, ongeveer 5 minuten in de vriezer (hangt van de temp in je vriezer af) en daarna weer uit de vriezer halen. Het overtollige water afgieten.
De beslagen onderkant droog vegen en direct met mobiel filmen en of foto’s maken, terwijl de dunne ijslaag weer smelt. Het is zo wonderlijk, verbazingwekkend, wat voor patronen Water dan creëert.
EN
A few years ago I learned the technique how to do chrystalographie with Water from Veda Austin’s teachings online. I will use this term all along.
1/3 of Water in a petri dish, as neutral as possible ask a question or ask Water to show what
she wants to show you at that moment. Put the dish in de freezer for about 5 minutes.
(depending on the temp in your freezer). Get the dish out of the freezer, pour away the
Water above the very thin frost layer, wipe with a dry clean cloth the bottom and make
video’s and or pictures immediately while the very thin frost layer is melting.
You will be so amazed by the different and beautiful patterns Water is showing you.